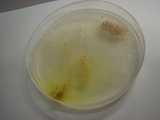

UP
2005年06月29日
ひびのくらし
昨日、ひ〜ひ〜いってた件は、あっさり解決。ソースを眺めて悩んでいるより、実際に手を動かすとあっさり解決しちゃうもんなのな。
夜、仏語教室。夏学期スタート。開講が危ぶまれていたが、結局 4名でスタート。しかも、そのうち1人は夏休み明けで渡仏。
ところで、今年の夏はなかなか面白そうな映画が多い
パリでポスターを見て、これは見たいと思いつつ見れなかった
der untergang ヒトラー 〜最期の12日間〜がやっと日本でも公開。
あと、WATARIDORIを越えるヒット と言われる
la Marche de l'empereur 皇帝ペンギン ただ、分類が「Jeunesse」で、le mondeの評価がそんなに良くない。ペンギンの声を訳者が吹き替えるというので、案外、日本の動物お涙映画と同系統なのかもしれないという不安はある。
邦画では「亡国のイージス」 自衛隊の協力により、モノホンのイージス艦やFー2戦闘機が見れると言うのは貴重かも。Fー2は 調達中止が決まった事だしな。
スターウオーズはどうしよっかな・・・・。ま、行くと思うけど、そんなに期待はしてないのね。
2005年06月28日
んな〜
キリキリはたらく。○○日までに出来ませんかね? と言われ、とりあえず頑張ってみますと答えて、残業代も出ないのに遅くまでガリガリやってる訳ですが、そういうのは評価されない訳で、こんな働き方しちゃホントはいかんと思う訳です。でも、プログラミングってのはそういう時でないと進まないんだよな〜 なんでだろ〜
んで、cgi scriptの機能追加と不具合対応。機能追加は、まあ、いいとして、不具合は原因がわからない。前、動作チェックしたときは何も問題が無かったのに・・・。
perl cgiから rubyのscriptを呼んで、rubyからさらにbinaryを呼んでいる。(rubyから先は他の人が作った) どうやら、この多重受け渡しで環境変数が渡ってない。SEさん、設定変えましたか?
ここまで気が付くのと、環境変数をのたくっているので半日消費。こういう時、cgiはデバッグしにくくて困る。
多重受け渡しをしている限り、その不具合はまた起こるかもしれないし、どーにも埒があかんので、ruby script部分をperlで書き直して、多重呼出しを減らす事にする。
電車がヤバい時間になる前に、目処が付いたところで帰る。
へろへろ・・・・
2005年06月26日
愛宕山
JMに誘われて、フランス人1 ニュージーランド人1 日本人2 で愛宕山へ登って来ました。 電車で嵐山まで出て、そこからバスで清滝
清滝から 空也の滝 -> 愛宕神社 -> 清滝 のルートで回りました。
登りは40分ほどで代謝パスのスイッチが入って楽に、ハイになって。
とわきろめーた ぴえー さゆーず さゆーず、 かときろめーたーぴえー、さゆーず すりえー
とか歌ってしまいました。
下りは膝がもう保ちません。膝がもうガクガクになってしまってダメです。英/日/仏 三ヵ国語で話してましたが、後半、疲れて来るとおもいっきり無口になりますね。
山頂付近の愛宕神社は 石階段とか見事で、どうやって物資を運んだかわからない。たいへん充実しておりましたです。
やせたかも と思いましたが、帰りに京都駅で チャーハンとラーメン喰ったので、使った分のカロリーは補給してしまったと思われます。

彼らは愛宕神社にお住いらしき猫の人。「なに見てんねん、われ」とか、言われてるのだろうか?
Petain 元師の歌
les choristes という映画を知らない人にはわからない話題ですが・・・。
子どもたちのコーラスのパートを決めるために、マチュー先生が1人づつ歌を歌わせるシーンがあります。
その中で、ある少年がMaréchal! Nous voilà! と祖父から習った歌を歌って、マチュー先生に「誰にならった? 古い歌だ」とゆーよーな事を言われるシーンがあるんです。他の子たちも古くからある歌を歌ってるのに、なぜわざわざ 古いと言うのかな? Maréchal(元師)というのはナポレオン時代の誰かかな? とか想像してたんですが、今日、友人のJMと話をしてて、「あれは Maréchal Pétain(ペタン元師)の事で、ヴィシーフランスの歌なんだよ」 と、教えてもらった。
あの映画の舞台は確か1950年代。マチュー先生が「誰に習った」とわざわざ聞くのはそういう歴史的背景があるからなんですね。
2005年06月25日
あち〜
あ〜ち〜。全然雨降らない。このままでは大変な事になりますよ。ホント!
で、暑い中、弓道の練習に行きましたが、首を寝違えてて ちゃんと的の方を向けません。そんなワケで、弦で頬を打ちまくりですよ。ばっちんばっちんと、も〜ね・・・。血は出ませんでしたが、痕になったりしたら、ヤダなぁ。でも、命中率は結構良い。良いんだけど、射形が大きくとれてない気がする。こんなんではきっといけない気がします。
夕方、仕事場に行って、perlのハッシュのリファレンスの勉強をかねて、色々やってみました。んで、また後戻り不能ですよ。前の汚いコードに戻すぐらいなら変えちまえ、と、そんなこんなで夜ですよ。ひ〜。
帰り、JR接続最悪で、3時間ぐらいかかる。ひ〜ひ〜
三菌志後伝

四日前にもはやこれまでという状態になっていた粘菌ちゃんを 2%ショ糖の寒天培地に移してあげた。どうやらショ糖だけでは栄養が足りないらしく、粘菌ちゃんは成長せず、カビも浸入せず、平和に寒天上で余生を送っている模様。
別のシャーレに酵母とか納豆菌とかも植えてみたけど、2%ショ糖ではダメっぽい。さて、どーしよう。
2005年06月24日
ひびのくらし
帰りの京阪電車でラボの人 2人と短期留学で来たフランス人SB嬢とバッタリ会う。ラボの人にフランス語で喋ってみてとか言われるが、そんな事言われましてもなぁ・・・。と、ゆー事で、
elle nous a dit que parlons-nous le française parce-que elle veut écouter sa prononciation.
A bon, ・・・・以下略
などと言う。
夕方から仏語教室。春学期最後の授業。最後だからか珍しく受講者が全員揃う。私はもう来学期の申し込みをしてしまったが、果して、この講座が存続できるかは謎。 8人中、フランス留学2人を入れて、4名が居なくなる。これはヤバいかも
参考:
同級生のムッシュー・森のページ
電波望遠鏡のペーパークラフト
パリティの今月号の閉じこみ付録が VESA電波望遠鏡のペーパークラフトだったので、思わず買いそうになる。が、「いや、きっとどっかWebにある筈だ」と思い直し探したところ、あっさり
国立天文台 ALMA HomePageで発見。無許可の直リンク禁止らしいので、トップ → キッズ → ペーパークラフトで参照のこと。
いやぁ、たまりませんなぁ。
2005年06月23日
ひびのくらし
きりきり働きます。こういう事もたまにはあります。急ぎの仕事の合い間に、perlのHTML::Templateモジュールの動作確認をしたところ、そのままscriptをリライトしてしまう。この作業は優先順位低いはずなのに、気が付いたらもう元に戻せない/止められない状態までscriptを書き変えてしまっていた。(ま、バックアップはとってありますが)
夕方、友人JMとフランスから来た学生さんとで茶飲み話をする。かなり聞きとれなくて凹む。漫然としていると、r音を聞き逃して未来なのか過去なのかわからなくなる。
JMもJLもゆっくり話す地方の出身なので聞き易かったが、彼女はサントルの人だそうだ。
こくーんでんせつ

今朝の女王陛下はアリ伝説のジェルの破片を幼虫の上に盛りつけたりしてなかなか面白い。餌を与えているつもりだったのかな?
さらに、夕方には、一匹が繭に、英語でゆーと こく〜ん フランス語で言うと ここん っていわはるんえ(京都風)
2005年06月22日
ひびのくらし
しごとする。
追加の作業依頼。
しごとする。
修正依頼。
しごとする。
追加の作業依頼。
・・・・・・・
どーしてキミ達はこう、同じ日にまとめて作業依頼して来るかな。
報告会が近いからか? そうなんだな?
仏語教室、来週から夏学期だが、またもや講座存続の危機。今回はまじでヤバそうな気配。もうそろそろ覚悟しておいた方がいいのかも
どーも、今年は色々なものが終っていく年の様だ・・・。
曲ってる?(アリ女王伝説)

アリの幼虫の人がでかくなってきた。
二匹とも、なぜか先端が曲ってるんですが、だいじょーぶだろうか?
あと粘菌はシャーレに避難させてやりましたが、もうダメっぽいです。
2005年06月21日
ひびのくらし

ガムを噛むと集中力が増して眠くならないという事なので、一日中ガムを噛み続ける。舌を何度も噛む。たしかに痛さで眼は醒めた。
ドイツの大学から短期交換留学(?)でフランス人学生が来る。大きい女性です。180cmぐらいありそうです。
夕方、ししゃもなどを炭火で焼くという行事が突発的に開かれたので、途中まで参加する。ビール一杯でもうフラフラです。エンドレスそうだったので8時に抜ける。
2005年06月20日
またいっぽ、さいきょうにちかずいた
ThinkPad i s30 ちゃんのキーボードをUSキーボードに換装する。作業5分。むしろ、ドライバの変更がわからなくて焦った。ENTERは打ち難くなったが、他はいい感じ。またいっぽ、さいきょうにちかずいた。
いきものばんざい
「生きてる限り みんなみんな友達〜♪」という主題歌の「いきものばんざい」という番組がありまして、またあの歌が聞きたいなと思う今日このごろ。
同僚のoreさんのトマトは実がなるわ、アリのお子さんは産まれるは、エビもいるわで 正に生き物万歳状態。いいなぁ

で、もう一匹の女王さまの方は この週末ようやく卵が孵化した裳様。幼虫と卵に分けて管理しているようです。

一方で粘菌の方はどうにも元気がない。酵母がいるにもかかわらず、クロカビにちょっかい出す粘菌さん。栄養が豊富すぎる状態ではかえってダメだという記述も発見。どーしたもんかな・・・。
2005年06月19日
神前結婚式
 |  |
八坂神社で和式の結婚式に遭遇。らっき〜。かみさま〜ありがとぉ〜
私は自分が和装するのは好きだが、他人の和装はどーでもいいのだが、神社の装束は見るのも好きである。別に巫女萌えとかいうのではないので念のため。
半矢
今日は武道センターで地連の審査だったので、見にいっても良かったのだけども、仏検の結果が惨々だったのでそんな気にはなれず。
かわりに道場へ練習へ行く。不思議な事に調子よし。16射まで半矢(つまり8中)。でん、矢飛びが良くない。夕方からU先生に見てもらう。矢飛び良くなる。 惨々だった結果もわすれて気持ちよく引きました。
平日も引けるといいんだけどね〜
仏検二級
仏検二級 2回目の受検です。今回は正直いいところまで行くと思っていました。が、しかし、穴埋め問題を全部落しました。読解は全部できました。聞き取りが半分。ディクテは書きはしましたが、アクサンとか落してるし、怪しいです。一次合格は60〜70点の間だと思いますが、おそらく数ポイント足りません。毎週行っているフランス語教室で、読解と会話と聞き取りは向上するのですが、穴埋めは試験対策しなきゃどーにもならなそうです。うーん、そういうお受検型の勉強は目茶苦茶苦手なんだなぁ・・・。もう凹みまくりですよ。しくしくしく
ストレスからやけ喰いする。げぷ。止めときゃよかった。
2005年06月18日
ひびのくらし

Thinkpad S30用のUSキーボードをポチって発注してしまう。(あわわ)
午後からベンチャービジネスの会議に、百万遍の薬学部まで出ばる。
どんなに革新的で面白い技術でも、それを産業化するには、地味な作業の集積が必要となるのだなぁ。
京都駅まで出る。ソフマップでUSB接続のDVDーRをすんでのところで買ってしまいそうになるが、自制する。
ヤマハの電気自動車が展示してあったので、物欲が激しく刺激される。総重量40キロでとても小さい。触ったり跨ったりしてみたかったけど、ダメっぽかったので諦める。たまにちょい乗りで遊ぶには面白そう。盗難とか心配かな。ひょいっと持って行けちゃう感じ。
あと、たぶんあんまりスピード出せないようになってるんじゃないかと思う。せいぜい30キロくらいしか出ないのかも。折り畳み自転車の高いヤツでもそれぐらいはいけると思うので、同じ値段突っこんで、折り畳み自転車の方が面白いかも知れない。
2005年06月15日
いきものばんざい
日曜はあれだけ探してみつかんなかった紫陽花だが、うちのラボのちかくでごっそり咲いているのを発見。
あ、さて粘菌の話題。複数ルートから なんでバイ菌飼ってるの? とか言われたので、本文とページを分けます。
ちみたちには、粘菌のロマンがわからんか! 熊楠先生もお嘆きになっているぞ(いや、知らんけど)
続きを読む
2005年06月14日
三菌志

MT嬢が置いていった粘菌床にはクロカビが繁殖し、いやな匂がしてきたので、糖分を含む寒天部分と液状化した酵母を除去し、新たに乾燥酵母を投入。その状態で週末放置プレイっておいたところ。
不思議な事に、クロカビは菌床表面ではなく、中の方に入り込んで繁殖。もしかして嫌気性? 酵母は以前程ヤワではなく、ある程度生き残る様になって来た。現在粘菌と交戦中。
あと、シャーレにて単独で繁殖中の粘菌を飢餓状態に置いて、さらに蛍光燈の下に放っておいたのだが、縮んだだけで胞子化せず。まだクリアすべき条件が必要なのか?
2005年06月13日
hikaru no Go tome 15

amazon.frに発注しておいたヒカルの仏語版の15巻が届く。同時に発注した16巻はバックオーダー 送料でかなり損してる感じ。
15巻は佐為が成仏してしまうので、ヒカルが「ああすればよかった、こうすればよかった」と過去を振り返って悩むので、条件法過去を使うシーンがある。
2005年06月12日
ひびのくらし

昼まで寝倒してしまった。午後から神社めぐりをする。なぜかというと、神社は無料だから。ま、おみくじ代とかお賽銭とかかかるけどね。
どーも、寺へは行く気がしないのであった。
困ったときの神頼み、お願いするだけでも気がまぎれるのが不思議。
むしろ、悩みを一歩引いて把握できるからだろうと思う。
紫陽花

どうにも紫陽花がみたくなり、原付にのってありそうなところを走り回ってみる。
いざ探すと見つからないものだのぉ
標高280m程の山の上にある神社のそばでひっそりと咲いているところを発見。
花弁の形が微妙に違う様な気がする。これは、山紫陽花なのかな?

その後、別の神社で鉢植えの紫陽花をみつける。
もっといっぱい見たいなぁ
萌絵馬

近所の神社で、萌絵の絵馬が奉納されていたのでびっくり。
そういう作品があるのだろうか?
どーやらOFF会をやったらしいが、天宇受売命の人も大変だな。
2005年06月11日
梅雨入り?
一日中小雨 梅雨入り?
昼から弓道の練習。 湿気でねっとりとした離れになる。
夕方、散髪にいく。
「丸坊主にしてください」
「ホントにいいの?」
「あ、やっぱ短めで」
うーん、勇気がないなぁ
2005年06月10日
ディスククラッシュ
パソコンから異音がする きーっちょん きーっちょんと鳴くのである。 どうもHDDからっぽい。と、同時に画面やマウスが停止してしまう。んで、そのままお亡くなりに・・・・。 データは データは〜。がーん、どうしよう。としばらく途方にくれる。
しばらく 大口を開けて放心しつつ真っ暗な画面を見てたのだが、念のため、PCの蓋を開けてみる。 あれ? HDDが二台ある。この瞬間まで、60Gと40Gの二台体制だった事を忘れていた。壊れたのは40Gの方で、主にWindowsとそのアプリが格納されていた。60Gの方にはLINUXが入っているのである。
異音のする40Gを切り放したところ、LINUXが問題無く起動。あー良かった。 失われたのはWINDOWSアプリとEXCEL表(家計簿)とかMP3とかMPEGのデータ。けっこうダメージだけど、メールとかデジカメのデータは無事だった方のディスクだったので、一安心。
しかし、Windowsが無いと某魔法のテクノロジで漫画を読んだりできなくなるのがちと痛い。でも、インストールするの面倒だしなぁ
。どーすっかなぁ・・・
2005年06月09日
献茶式

近江神宮の献茶式へ和服着て行く。仕事は年休とりました。
ちょっと寝坊して、遅れて到着したところ、もう儀式は始まってしまっていて、参列者座席に入り難い状況になってしまっていたので、そのまま立ったまま後で見る。(が、かえってこっちの方が儀式が良く見えた。) この人は日本の茶道界の頂点に立つ流派の先代の家元さま。
茶道をやってる人は感動してるっぽいが、わたしはやってないので、
凄さがよくわかりません この人のやっていたNHK人間講座「茶の心」は見てましたが、特攻隊の話をしていた事しか憶えてません(おいおい)。ともあれ、凄い人だそうです。だいそうじょうさま(?)だそうです。RPGで言えばラスボスですな。
儀式修了後、立礼と薄茶席と点心がある。立礼にいくと「お正客していただけませんか?」と言われる。正客というのは、一番最初にお茶を出されて、いろいろ儀式とか問答とかある役なのだ。もちろん断わる。男性が着物を着て行くとかなりの高確率でそういう事を言われるそうだ。 四人目だったけど、たて出しだったので、のほほんしている。お菓子は「かるかん」。凄い席なのかもしれないが、
素人なのでやっぱりわからない
次、薄茶席。 外国人研修者の人達と同席になる。この人たちの中には海外ですでに家元として活躍してる人とかもいて、実はほとんどプロなのだそうだ。 が、そんな説明とかはもうどーでもよくて、今度は正坐しなくちゃいけなかったので、足が痛くてダメ。気を失いそう。 痺れるとか、ヒザとかじゃないのよ、親指の付け根が千切れそうに痛いのよ(なぜか)。 お菓子は 葛饅頭。
最後、点心。これは食堂で弁当もらって食べるだけ。もくもくもく
ま、なかなかに面白かったです。
2005年06月08日
ひびのくらし
仕事する。合い間に雑談してたらGTせんせーに呼ばれる。
さらに仕事する。合い間に粘菌みてたらGTせんせーにみつかる。ちゃんと仕事してましたよ(ごぜんちゅうは) ホントですよ、嘘じゃないです。
K山さんがごま饅頭をもってくる。生協で王将アイスを買ったらアタリが出る。ガムをねだったら山盛もらう。夜、蕎麦屋に入ったらサービスで売れ残りのおむすびをもらう。 そういうささやかな幸せはたしかに嬉しいですが、その、なんか ね もっとこうズガーンと大きな好運はなんとかならんもんでしょーかね?>神。(あ、Intelligent Design っつーんですかね 最近は)
つーか、ダイエットしよーというの私の希望を邪魔しようとしているんですか?
閑話休題 タッパーの寒天培地(昨日の日記参照) 粘菌はクロカビから逃げようとしている模様。 そしてその後にうっすらと酵母の生き残りを発見。なぜか増殖しているっぽい。三菌志のはじまりか! カメラ忘れたので撮影できませんが、明後日 再確認する予定。
2005年06月07日
粘菌 対 ビール酵母 寒天上の決戦
|  |
| 酵母勝ち | 粘菌勝ち |
粘菌 対 ビール酵母。菌国の興亡 この一戦にアリ。
やはり元気が無かった方の粘菌は酵母の量に圧到されて負けてしまっていたようだ。黄色く見えている固まりは単に色素が残っているだけで、その下にいるのは酵母だと考えられる。前線(細胞膜)は随処で切断され、修復の見込み起たず 原形質と核をまき散らした状態で 酵母にいいように蹂躙されている模様。(って、想像だけど) やっぱ、こいつらも他の生物を圧到する為になんらかの蛋白毒素を出してるんだろうねぇ
一方、酵母を少めに与えた方の粘菌はビール酵母を駆逐 つぎなる獲物を求め寒天上を移動中。だがそこに新たなる敵、クロカビの浸入が! 粘菌はクロカビに勝てるのか? 餌の酵母を小量ずつ投与してやるべきか?
あと、NTさんがカフェテリアのサラダの中に小さなイモムシを発見。あやういところであった。とりあえず捕獲。MT嬢からは、アリの生き餌にすべしとの大胆な提案・・・。生物学者おそるべし・・・
2005年06月06日
あこがれの粘菌せーかつ しょにょ3
週開け、酵母を大量に与えたシャーレの粘菌は 数は増加したが、どうも境界がはっきりしない感じ。与えすぎか?
タッパーで育てている粘菌ちゃんは、タッパーの端から端まで移動し獲物を探している模様。酵母を振りかけてやったところ、もう、群がる群がる。こえ〜
こいつらが移動しているところを撮影したいのだけど、光に当てると ほぼ一時間で胞子体へ不可逆変化してしまうそうな。(だから、とりだして眺めすぎるとダメらしい) 変化しない波長はわかっているそうなので、そういう撮影系を用意するのも手かも。
2005年06月04日
結婚式

大学時代の同期の結婚式へ行く。式場は名古屋駅前のマリオットなんちゃらホテル。外見の巨大さとバブリーな設計から、中身もそうかと思いきや、中はけっこう普通っぽい。結婚式と披露宴の両方に参列してきた。
結婚式中の撮影は許可されていなかったので、写真は式前に並んだところ。
キリスト教式の結婚式で、いきなり外国人の牧師さんが出てきたのにはビックリ。日本語と英語話してました。
大学時代の同期の参加者はKH,KS,YMと私。四年間遊びほうけてたよーなきがするが、あの頃は毎日がイベントだった。 新郎のKTは率先してバカをやる親分だった。後先考えずに無茶をする男だった。彼が幸せな家庭を築けるかどうかは未知数だが、ハチャメチャでおもろかしい家庭を築く事は間違いないと思う。
○○リウム祭り
友人の結婚式に名古屋駅前のホテルに行ってきたのだけど、集合時間前にハンズへよってきた。 アントクとかエビちゃんとかビンに入った魚とか売ってました。うひょ〜
んでも、こんな風に陳列して大丈夫かな? 特に、魚 弱って死んじゃわないかな?
エビちゃんはかなり欲しかったのですが、輸送に問題がありそうだったのでやめました。
かわりにアクリル滅菌シャーレを数個 買ってきました。これで
- 納豆菌 vs 酵母菌 vs 粘菌 題して 三菌志
- 粘菌の迷路探索
などをやってみる予定。ウエット系を仕事にしとろ言われると辛いもんがあるが、趣味的にこういうのをやるは面白い。あと、シアノちゃんは手に入りませんかね?>S氏
2005年06月03日
あこがれの粘菌せーかつ しょにょ2

やばい、粘菌 まじやばい
酵母なんぞは敵ではない。もりもり喰っちゃってる。
写真は左右から酵母を包囲しよーとしている粘菌
粘菌は眼が無いのに 食べ物の在処がわかる様だ 乾燥酵母をシャーレの反対側に撒いて 20分もほっとくと、もうそっち方向へ向かっている。 こえ〜
しかも、こいつは これで 一個の細砲なのだ。
そのかわり細胞膜の中に核がいっぱいある。
今日、餌をやるとき、手許が狂って 酵母をどっさりとシャーレに撒いてしまった。 酵母も数が多ければ 数で敵を圧到して生きのびられるんじゃないかと思うんだが、寒天に養分が無いから、酵母側不利なのかも
と、いう事で 酵母ちゃん達は週末を生きのびる事ができるのであろーか?
2005年06月02日
de Villepin
EU憲法条約批准 拒否を受けて、Raffarin 更迭で Villepin新首相が誕生したわけですが〜。
素朴な疑問。Villepin 氏の呼び方が日本では ドビルパンと、ドをくっつけちゃってるんだけど、この「de」を付ける付けないはフランスではどーゆー規準になってるんでしょーかね?
ちなみに、le monde は de Villepin
Libération と le figaroは Villepin ただし、フルネームの時はDominique de Villepinとde付き。
あこがれの粘菌せーかつ
 |  |
| 10:30 | 17:45 |
ntさんの乾燥粘菌を寒天シャーレの上に住まわしてみたところ。いい具合に拡がって来ました。寒天に栄養を添加していないので、餌として乾燥ビール酵母を与えてみました。今後、カビとか納豆菌とかと闘わせてみようと思ってるところ。そうなると、寒天に栄養があった方がいいのかな。
2005年06月01日
la reine des fourmi et ses oeuf
虫眼鏡を買って来た。まさに、まさに 虫を見るための眼鏡。ああ、すばらしきかな虫眼鏡
女王陛下とその御卵さまであらせられます。 女王陛下がお産みになったからといって、御卵様には王位継承権はないのであります。